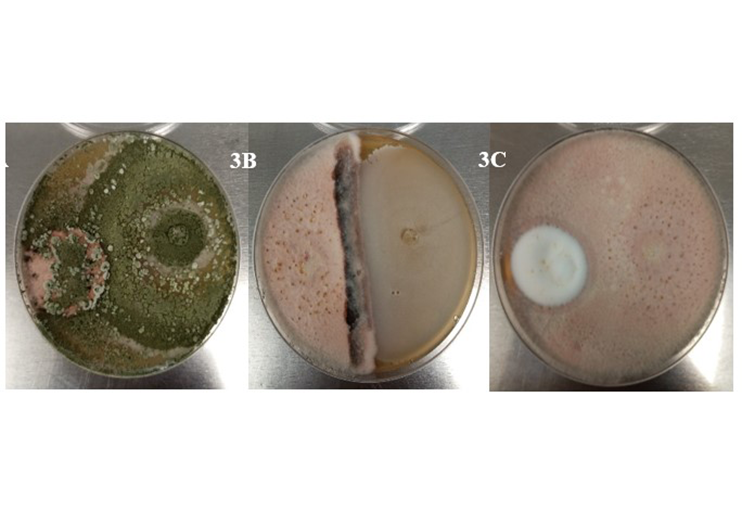

Control biológico de antracnosis utilizando microorganismos antagonistas en Coffea arabica en el Estado de México
DOI:
https://doi.org/10.29312/remexca.v16i7.3876Palabras clave:
Bacillus sp, Colletotrichum sp, Trichoderma sp., Verticillium spResumen
El café en México es importante para la economía, generando empleos y divisas; no obstante, enfrenta problemas fitosanitarios como la antracnosis, causada por el hongo Colletotrichum sp., la cual, se maneja a través de productos químicos, afectando al medio ambiente, por lo que se hace necesario buscar alternativas más amigables para el control de esta enfermedad. El objetivo de la investigación fue evaluar el efecto antagonista de tres microorganismos (Trichoderma sp., Bacillus sp. y Verticillium sp.) frente a Colletotrichum sp., en muestras colectadas en los municipios de Temascaltepec y Tejupilco, Estado de México en diferentes fechas del año 2024. El experimento se realizó en el laboratorio de Fitopatología del Instituto de Investigación y Capacitación Agropecuaria, Acuícola y Forestal del Estado de México. Se realizó la confrontación In vitro de las cepas antagónicas frente a Colletotrichum sp., calculando con el software ImagenJ: a) grado de micoparasitismo y b) porcentaje de inhibición de crecimiento. Para determinar el modo de acción del antagonismo, se realizó un Anova y una comparación de medias de Tukey (p> 0.05). Se observó que Trichoderma sp., presentó el mayor grado de inhibición sobre el fitopatógeno con 85.15%, Bacillus sp., con 59.27% y Verticillium sp., con 47.08%. Se concluyó que Trichoderma sp., fue el microorganismo que tiene el mayor efecto antagonista, lo que sugirió la viabilidad de realizar investigaciones en campo, para evaluar el impacto de este microorganismo en el control de la enfermedad en condiciones naturales.
Descargas
Citas
Bibliografía
AlAVO, T. B. 2015. The insect pathogenic fungus Verticillium lecanii (Zimm.) Viegas and its use for pests control: a review. Journal of Experimental Biology and Agricultural Sciences. 3(4):337-345. https://doi.org/10.18006/2015.3(4).337.345.
Amaro, J. K. C.; Vieira, B. S. and Sousa, L. A. 2018. Biological control of Colletotrichum gloeosporioides in pepper with isolates of Bacillus subtilis. Brazilian Journal of Agriculture. 93(2):195-209. https://doi.org/10.37856/bja.v93i2.3299.
Araya, C. A.; Benavides, I. V. y Torres, S. 2019. Inhibición del crecimiento micelial de hongos asociados a antracnosis en ñame (Dioscorea alata). Agronomía Mesoamericana. 30(2):381-393. https://www.scielo.sa.cr/pdf/am/v30n2/2215-3608-am-30-02-00381.pdf.
Astorga-Quirós, K.; Meneses-Montero, K.; Zúñiga-Vega, C.; Brenes-Brodeurdriz, J. A. y Rivera-Méndez, W. 2014. Evaluación del antagonismo de Trichoderma y Bacillus subtilis contra tres patógenos del ajo. Revista Tecnología en Marcha. 27(2):82-91. https://doi.org/10.18845/tm.v27i2.1929.
Bastos-Osorio, L. M.; Salazar-Escalante, R. Y.; Mora-Carvajal, C. y Duarte-Cristancho, M. 2019. Análisis de las tendencias en la producción y el consumo de café a nivel internacional. Revista Visión Internacional. 1(1):22-26. https://doi.org/10.22463/27111121.2369.
Bello, C. J. C.; Figueroa, T. R. F.; Guamán, M. M. M.; Villao, N. F. A. A. y Tumbaco, B. M. V. 2018. Prevalencia y diseminación de Verticillium sp. para el control biológico de la roya del café. Reciamuc. 2(3):92-119. https://doi.org/10.26820/reciamuc/2.(3).septiembre.2018.92-119.
Cannon, P. F.; Damm, U.; Johnston, P. R. and Weir, B. S. 2012. Colletotrichum: current status and future directions. Studies in Mycology. 73(1):181-213. https://doi.org/10.3114/sim0014.
Domínguez-Guerrero, I. P.; Mohali-Castillo, S. R.; Marín-Montoya, M. A. y Pino-Menesini, H. B. 2012. Caracterización y variabilidad genética de Colletotrichum gloeosporioides sensu lato en plantaciones de palma aceitera (Elaeis guineensis) Jacq. en Venezuela. Tropical Plant Pathology. 37(2):108-122. https://doi.org/10.1590/S1982-56762012000200003.
Espinoza, A. E. E.; Guadalupe, C. S. A.; Gallegos, J. L. H.; Latorre, C. R. C. y Robalino, H. S. R. 2017. Análisis económico del control biológico de la araña roja (Tetranychus sp.) en el cultivo de la rosa a través de la aplicación del hongo entomopatogeno (Verticillium Lecanii). Ecuador. European Scientific Journal. 13:40-52. Doi: 10.19044/esj.2017.v13n13p240.
Ezziyyani, M.; Pérez, S. C.; Requena, M. E.; Rubio, L. y Candela, M. E. 2004. Biocontrol por Streptomyces rochei Ziyani, de la podredumbre del pimiento (Capsicum annuum L.) causada por Phytophthora capsici. Anales de Biología. 26:69-78. https://revistas.um.es/analesbio/article/view/30471.
García-Velasco, R.; Alonso-Baena, A.; Domínguez-Arismendi, G.; Aguilar-Medel, S.; Mora-Herrera, M. E. y Companioni-González, B. 2021. Antagonismo in vitro de cepas nativas de Trichoderma spp. contra Verticillium dahliae y Botrytis cinerea en el Estado de México. Agronomía Tropical. 71:1-13. https://doi.org/10.5281/zenodo.5091830.
Guzmán, O. A. y Rivillas, C. A. 2005. Producción in vitro de conidios de Cercospora coffeicola. Cenicafé. 56(1):67-78. http://hdl.handle.net/10778/166.
Hyde, K. D.; Cai, L.; McKenzie, E. H. C.; Yang, Y. L.; Zhang, J. Z. and Prihastuti, H. 2009. Colletotrichum: a catalogue of confusion. Fungal Diversity. 39(1):1-17. https://www.researchgate.net/publication/274385803.
Martínez, D. I. y Coca, B. M. 2020. Antagonismo de seis cepas de Trichoderma asperellum Samuels, Lieckfeldt and Nirenberg sobre Colletotrichum spp. Revista de Protección Vegetal. 35(3):1-5. https://censa.edicionescervantes.com/index.php/RPV/article/view/1100.
Pérez, D. y García, G. P. 2019. Identificación del agente causal del marchitamiento en Caesalpinia spinosa tara y el efecto antagónico de aislados de Bacillus spp. y Trichoderma sp. Ecología Aplicada. 18(1):51-57. http://dx.doi.org/10.21704/rea.v18i1.1306.
Quintana-Obregón, E. A.; Plascencia-Jatomea, M.; Sánchez-Mariñez, R. I.; Rosas-Burgos, E. C. y Cortez-Rocha, M. O. 2010. Inhibición del crecimiento radial in vitro de la Fusarium verticillioides en presencia de quitosano. Revista Iberoamericana de Polímeros. 11(6):386-391. https://www.researchgate.net/publication/269698958.
Rengifo, H. G.; Leguizamon, J. E. y Riaño, N. M. 2002. Algunos aspectos biológicos de Cercospora coffeicola. Cenicafé. 53(3):167-177. http://hdl.handle.net/10778/1023.
Rojo-Bí, I.; García-Estrada, R. S.; León-Fí, J.; Sañodo-Barajas, A. y Allende-Molar, R. 2017. Estado actual de Colletotrichum spp. en México: taxonomía, caracterización, patogénesis y control. Revista Mexicana de Fitopatología. 35(3):549-570. https://doi.org/10.18781/r.mex.fit.1703-9.
Ruíz-Campos, C.; Umaña-Rojas, G. y Gómez-Alpízar, L. 2022. Identificación multilocus de especies de Colletotrichum asociadas a la antracnosis de papaya. Agronomía Mesoamericana. 33(1):1-8. https://doi.org/10.15517/am.v33i1.45495.
Sanmartín, N. P.; López, X.; Pemberthy, M. P.; Granada, S. D. y Rueda, E. A. 2012. Análisis del modo de acción y de la capacidad antagónica de Trichoderma asperellum sobre Colletotrichum y Fusarium sp. Revista Tumbaga. 2(7):29-49. http://revistas.ut.edu.co/index.php/tumbaga/article/view/36/353.
SENASICA. 2014. Antracnosis del cafeto (Colletotrichum kahawae J. M. Waller & Bridge). Dirección General de Sanidad Vegetal Programa Nacional de Vigilancia Epidemiológica Fitosanitaria. México, DF. Ficha técnica núm. 42. 9 p.
Sharma, A.; Sharma, S. y Yadav, P. K. 2023. Hongos entomopatógenos y su relevancia en la agricultura sostenible: una revisión. Cogent Food Agric. 9(1):2180857. Doi: 10.1080/23311932.2023.2180857.
SIACOM. 2022. Sistema de Información Agroalimentaria de Consulta. https://www.gob.mx/siap/documentos/siaconng-161430.
Sood, M.; Kapoor, D.; Kumar, V.; Sheteiwy, M. S.; Ramakrishnan, M.; Landi, M.; Araniti, F. y Sharma, A. 2020. Trichoderma los ‘secretos’ de un agente de control biológico de múltiples talentos. Plantas. 9(6):762-766. https://doi.org/10.3390/plants9060762.
Suárez, M. C. L.; Fernández, B. R. J.; Valero, N. O.; Gámez, C. R. M. y Páez, R. A. R. 2008. Antagonismo in vitro de Trichoderma harzianum Rifai sobre Fusarium solani Mart. Sacc. Asociado a la marchitez en maracuyá. Revista Colombiana de Biotecnología. 10(2):35-43. https://www.redalyc.org/pdf/776/77610205.pdf.
Zúñiga, E. M.; Merlos, J. B.; Sánchez, B. C.; Pérez-Pérez, R. y Avilés, M. C. 2019. Evaluación de metabolitos antifúngicos obtenidos en medio PD mediante el cultivo y co-cultivo de Bacillus subtilis y Trichoderma spp. sobre el crecimiento de Colletotrichum gloeosporioides y Fusarium oxysporum. Seguridad Alimentaria. 7-15 pp. https://www.researchgate.net/publication/332100019.
Descargas
Publicado
Cómo citar
Número
Sección
Licencia
Derechos de autor 2025 Revista Mexicana de Ciencias Agrícolas

Esta obra está bajo una licencia internacional Creative Commons Atribución-NoComercial 4.0.
Los autores(as) que publiquen en Revista Mexicana de Ciencias Agrícolas aceptan las siguientes condiciones:
De acuerdo con la legislación de derechos de autor, Revista Mexicana de Ciencias Agrícolas reconoce y respeta el derecho moral de los autores(as), así como la titularidad del derecho patrimonial, el cual será cedido a la revista para su difusión en acceso abierto.
Los autores(as) deben de pagar una cuota por recepción de artículos antes de pasar por dictamen editorial. En caso de que la colaboración sea aceptada, el autor debe de parar la traducción de su texto al inglés.
Todos los textos publicados por Revista Mexicana de Ciencias Agrícolas -sin excepción- se distribuyen amparados bajo la licencia Creative Commons 4.0 atribución-no comercial (CC BY-NC 4.0 internacional), que permite a terceros utilizar lo publicado siempre que mencionen la autoría del trabajo y a la primera publicación en esta revista.
Los autores/as pueden realizar otros acuerdos contractuales independientes y adicionales para la distribución no exclusiva de la versión del artículo publicado en Revista Mexicana de Ciencias Agrícolas (por ejemplo incluirlo en un repositorio institucional o darlo a conocer en otros medios en papel o electrónicos) siempre que indique clara y explícitamente que el trabajo se publicó por primera vez en Revista Mexicana de Ciencias Agrícolas.
Para todo lo anterior, los autores(as) deben remitir el formato de carta-cesión de la propiedad de los derechos de la primera publicación debidamente requisitado y firmado por los autores(as). Este formato debe ser remitido en archivo PDF al correo: revista_atm@yahoo.com.mx; revistaagricola@inifap.gob.mx.
Esta obra está bajo una licencia de Creative Commons Reconocimiento-No Comercial 4.0 Internacional.


